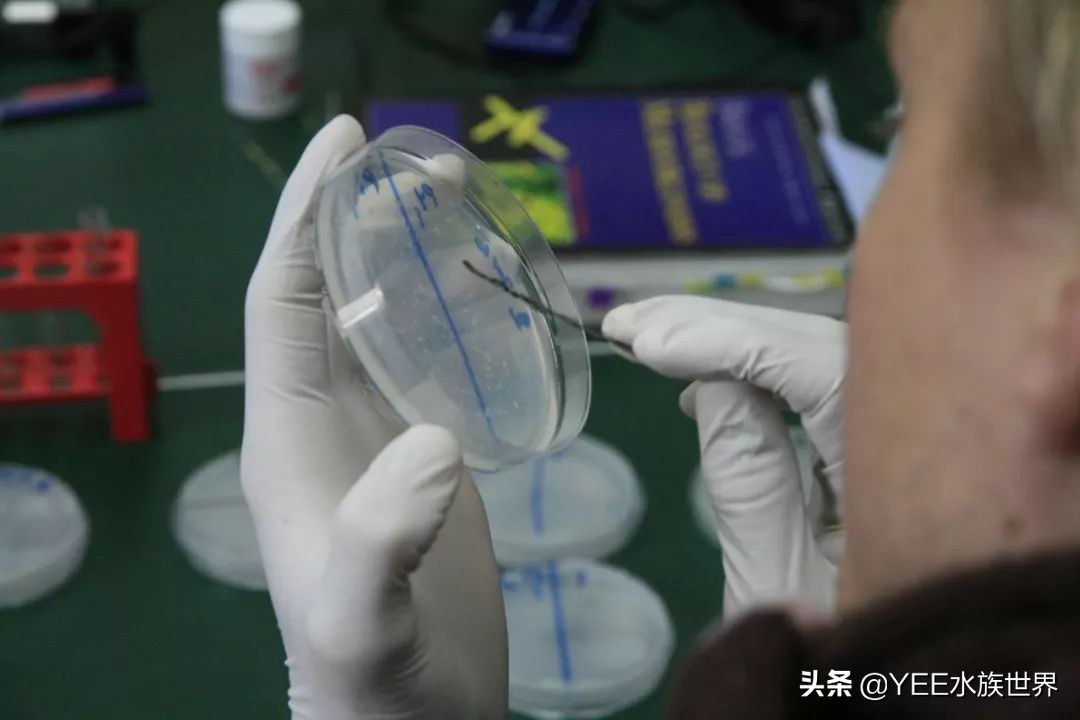
养鱼em菌的正确使用方法,在水产养殖中em菌是起什么效果

EM菌,直译是:有益的微生物。因为细菌也属于微生物,所以可以把EM菌叫做有益菌。
说到有益菌,其实我首先想到的是益生菌酸奶。据说这种酸奶里含有益生菌,能提高免疫力,对身体健康有利。现在去任何一个超市,基本都能看到含有益生菌的酸奶。

图片来源丨Pixabay 摄影丨jamie_nakamura
既然益生菌酸奶对身体有益,那同为有益菌的EM军,会不会也能在水产中大放光彩?
广义的EM菌有包括乳酸菌在内的80多种,它于上世纪80年代被日本人研究出来,现在市面上水族用的EM菌主要包含了四种菌群:光合菌,乳酸菌、酵母菌、放线菌。

图片来源丨Unsplash 摄影丨luiskcortes
光合菌几乎无处不在。它可以降解氨氮跟硫化氢,用在鱼缸中效果很好,能避免观赏鱼中毒。
说到光合菌,可能很多人会联想到“光合作用”这个词。植物在有光状态下进行光合作用净化水质。两者虽然都有“光合”这个词,但本质区别还是比较明显的。光合菌厌氧,降解氨氮而不产生氧,而植物的光合作用不吸收氨氮,但会产生氧。也就是说,光合菌跟植物不能相互替代。

图片来源丨Unsplash 摄影丨boxedwater
乳酸菌可以保护肠胃,促进消化,减少有害的毒素。这个特性让它可以活跃在很多领域中,除了饮食跟水产中,还能在医疗卫生领域使用。
乳酸菌本身没毒,目前我还没了解到有谁喝了含有乳酸菌的奶出现身体不适的。不过人体中有各种各样的细菌,当这些细菌维持在某个平衡点时,我们可以健康生活,而某一部分摄入太多还是会出问题。同理鱼缸中也是一样,理性使用,省钱也省事。

图片来源丨Pexels 摄影丨rawpixel.com
酵母菌是一类像乳酸菌一样被大家熟知的菌类。它可以用来酿酒、蒸馒头。这是一种繁殖能力很强的菌类,放在鱼缸里,主要是让它跟有害菌抢夺食物。以此饿死有害菌。酵母菌在分解糖类等有机物时,可以产出酒精跟水,或者二氧化碳跟水。
不管是哪种,都不会对观赏鱼造成影响。而当它繁殖到一定程度,又会快速衰竭下去,想继续使用就要重新放酵母菌。不过单独使用酵母菌的效果有限,大家还是愿意把它跟其他菌类一起使用,共同作用的结果,比单独使用酵母菌要好得多。
图片来源丨Flickr 摄影丨Pieter van Boheemen
放线菌可以分解有机物跟一部分有毒性的化合物。常用于污水净化跟废物处理中,据说还能促进土壤形成团粒结构而改善土壤。
不过由于放线菌种类比较多,也不都是有益菌,有一些会造成相应的病症。在众多放线菌中,有一些可以产生抗生素,杀掉细菌或抑制细菌繁殖,减少鱼病发生。

图片来源丨Unsplash 摄影丨nathadej
这四大类菌,成了EM菌的主要成分。它们各司其职,又相互需要,跟硝化细菌一起组成了良好的鱼缸环境。
EM菌可以分解有机物,而硝化细菌可以降解有机物被某些细菌分解后产生的氨氮跟亚硝酸盐。

图片来源丨Pixabay 摄影丨bboellinger
两种菌不冲突,可以同时使用。有一些商家直接将EM菌跟硝化细菌同时包装销售,其实也是没有问题的。
只是鱼缸中最好还是以硝化细菌为主,EM菌种类繁多,想保持多种菌的平衡,似乎不是一件很简单的事情。
文章由意牌旗下【YEE水族世界】原创,转载请联系作者